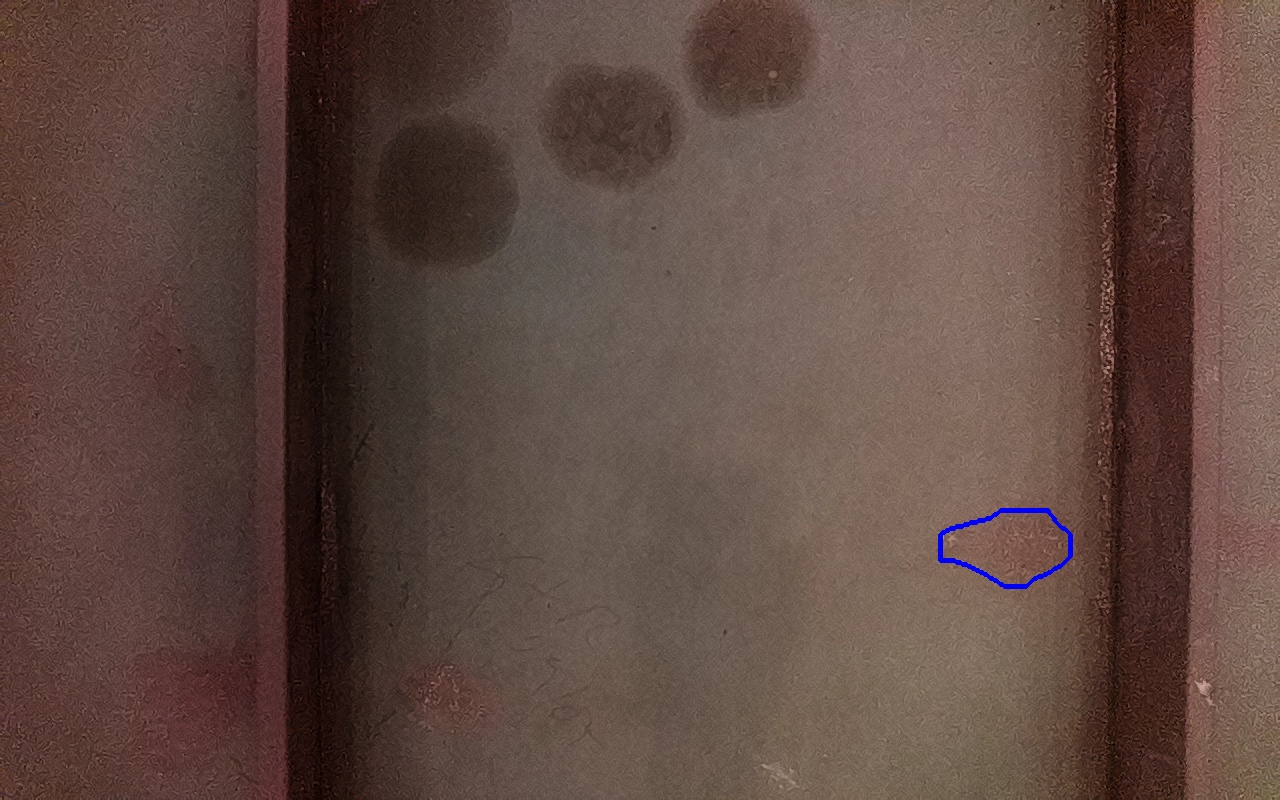

Discontinuidad detectada
| Tipo |
IV-4
Depósitos de óxido férrico débilmente adherido. |
|---|---|
| Fecha | 24/09/2025 09:52 |
| Tamaño (mm) | 4541 mm2 |
| Tamaño (m) | 0.0045 m2 |
| Confianza | 4.19 % |
| Posición |
X: 2.53 Y: -0.39 Z: 0.01 |
| Resultado |